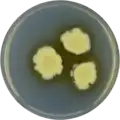
Aspergillus navahoensis growing on CYA plate

Aspergillus navahoensis
| Aspergillus navahoensis | |
|---|---|
| Scientific classification | |
| Kingdom: | Fungi |
| Division: | Ascomycota |
| Class: | Eurotiomycetes |
| Order: | Eurotiales |
| Family: | Aspergillaceae |
| Genus: | Aspergillus |
| Species: | A. navahoensis
|
| Binomial name | |
| Aspergillus navahoensis M. Christensen & States (1982)[1]
| |
Aspergillus navahoensis is a species of fungus in the genus Aspergillus. It is from the Nidulantes section.[2] The species was first described in 1982.[1] It was isolated from sand in Arizona, United States.[2] It has been reported to produce averufin, norsolorinic acid, 6,7,8-trihydroxy-3-methylisocoumarin,[3] desferritriacetylfusigen, echinocandin B,[4] and sterigmatocystin.[5]
Growth and morphology
A. navahoensis has been cultivated on both Czapek yeast extract agar (CYA) plates and Malt Extract Agar Oxoid® (MEAOX) plates. The growth morphology of the colonies can be seen in the pictures below.
-
Aspergillus navahoensis growing on CYA plate
Aspergillus navahoensis growing on CYA plate -
 Aspergillus navahoensis growing on MEAOX plate
Aspergillus navahoensis growing on MEAOX plate
References
- ^ a b Christensen, M.; States, J.S. 1982. Aspergillus nidulans group: Aspergillus navahoensis, and a revised synoptic key. Mycologia. 74:226-235
- ^ a b Chen, A.J.; Frisvad, J.C.; Sun, B.D.; Varga, S.; Kocsubé, S.; Dijksterhuis, J.; Kim, D.H.; Hong, S.-B.; Houbraken, J.; Samson, R.A. (2016). "Aspergillus section Nidulantes (formerly Emericella): Polyphasic taxonomy, chemistry and biology". Studies in Mycology. 84: 1–118. doi:10.1016/j.simyco.2016.10.001. PMC 5198626. PMID 28050053.
- ^ Yamazaki M, Satoh Y, Maebayashi Y, et al. (1988). Monoamine oxidase in- hibitors from a fungus, Emericella navahoensis. Chemical and Pharma- ceutical Bulletin 36: 670–675.
- ^ de la Cruz M, Martin J, Gonzales-Menedez V, et al. (2012). Chemical and physical modulation of antibiotic activity in Emericella species. Chemistry and Biodiversity 9: 1095–1113.
- ^ Frisvad JC (1985). Secondary metabolites as an aid to Emericella classification. In: Advances in Penicillium and Aspergillus systematics (Samson RA, Pitt JI, eds), NATO ASI Series. Ser. A.: Life Sciences, Vol. 102. Plenum Press, New York: 437–443.